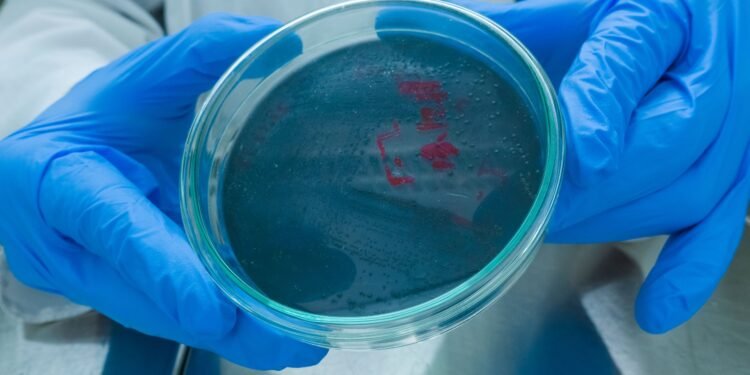
O româncă a murit de antrax

O femeie de 50 de ani din județul Ialomița a murit din cauza antraxului, o boală infecțioasă rară, dar gravă, provocată de o bacterie numită Bacillus anthracis. Aceasta poate fi contractată prin contact direct cu animale infectate sau produse provenite de la acestea, cum ar fi pielea, lâna sau carnea.
Potrivit unor surse citate de Știrile ProTV, femeia a fost dusă de urgență la spitalul din Slobozia, cu simptome precum amețeli și dureri de cap. Starea ei s-a deteriorat rapid, fiind transferată la un spital din București, unde, din păcate, medicii nu au mai putut să o salveze.
După decesul pacientei, autoritățile medicale au extins investigațiile și la membrii familiei. Fiul femeii, în vârstă de 20 de ani, și soțul ei, de 56 de ani, au fost internați la Institutul „Matei Balș”, unde medicii au observat pe pielea tânărului leziuni suspecte, specifice infecției cu antrax. Au fost recoltate probe și trimise pentru analiză la Institutul Cantacuzino. Testul PCR a confirmat prezența bacteriei Bacillus anthracis.
Antraxul nu se transmite de la om la om, ci, de regulă, prin contact cu animale infectate sau produse contaminate. În forma cutanată, cea mai frecventă, bacteria pătrunde în organism prin leziuni ale pielii. Simptomele pot include febră, leziuni dureroase pe piele, amețeli și stare generală de rău. În lipsa unui tratament rapid, boala poate deveni fatală.
Autoritățile sanitare continuă ancheta pentru a identifica sursa exactă a infectării și pentru a preveni răspândirea bolii.